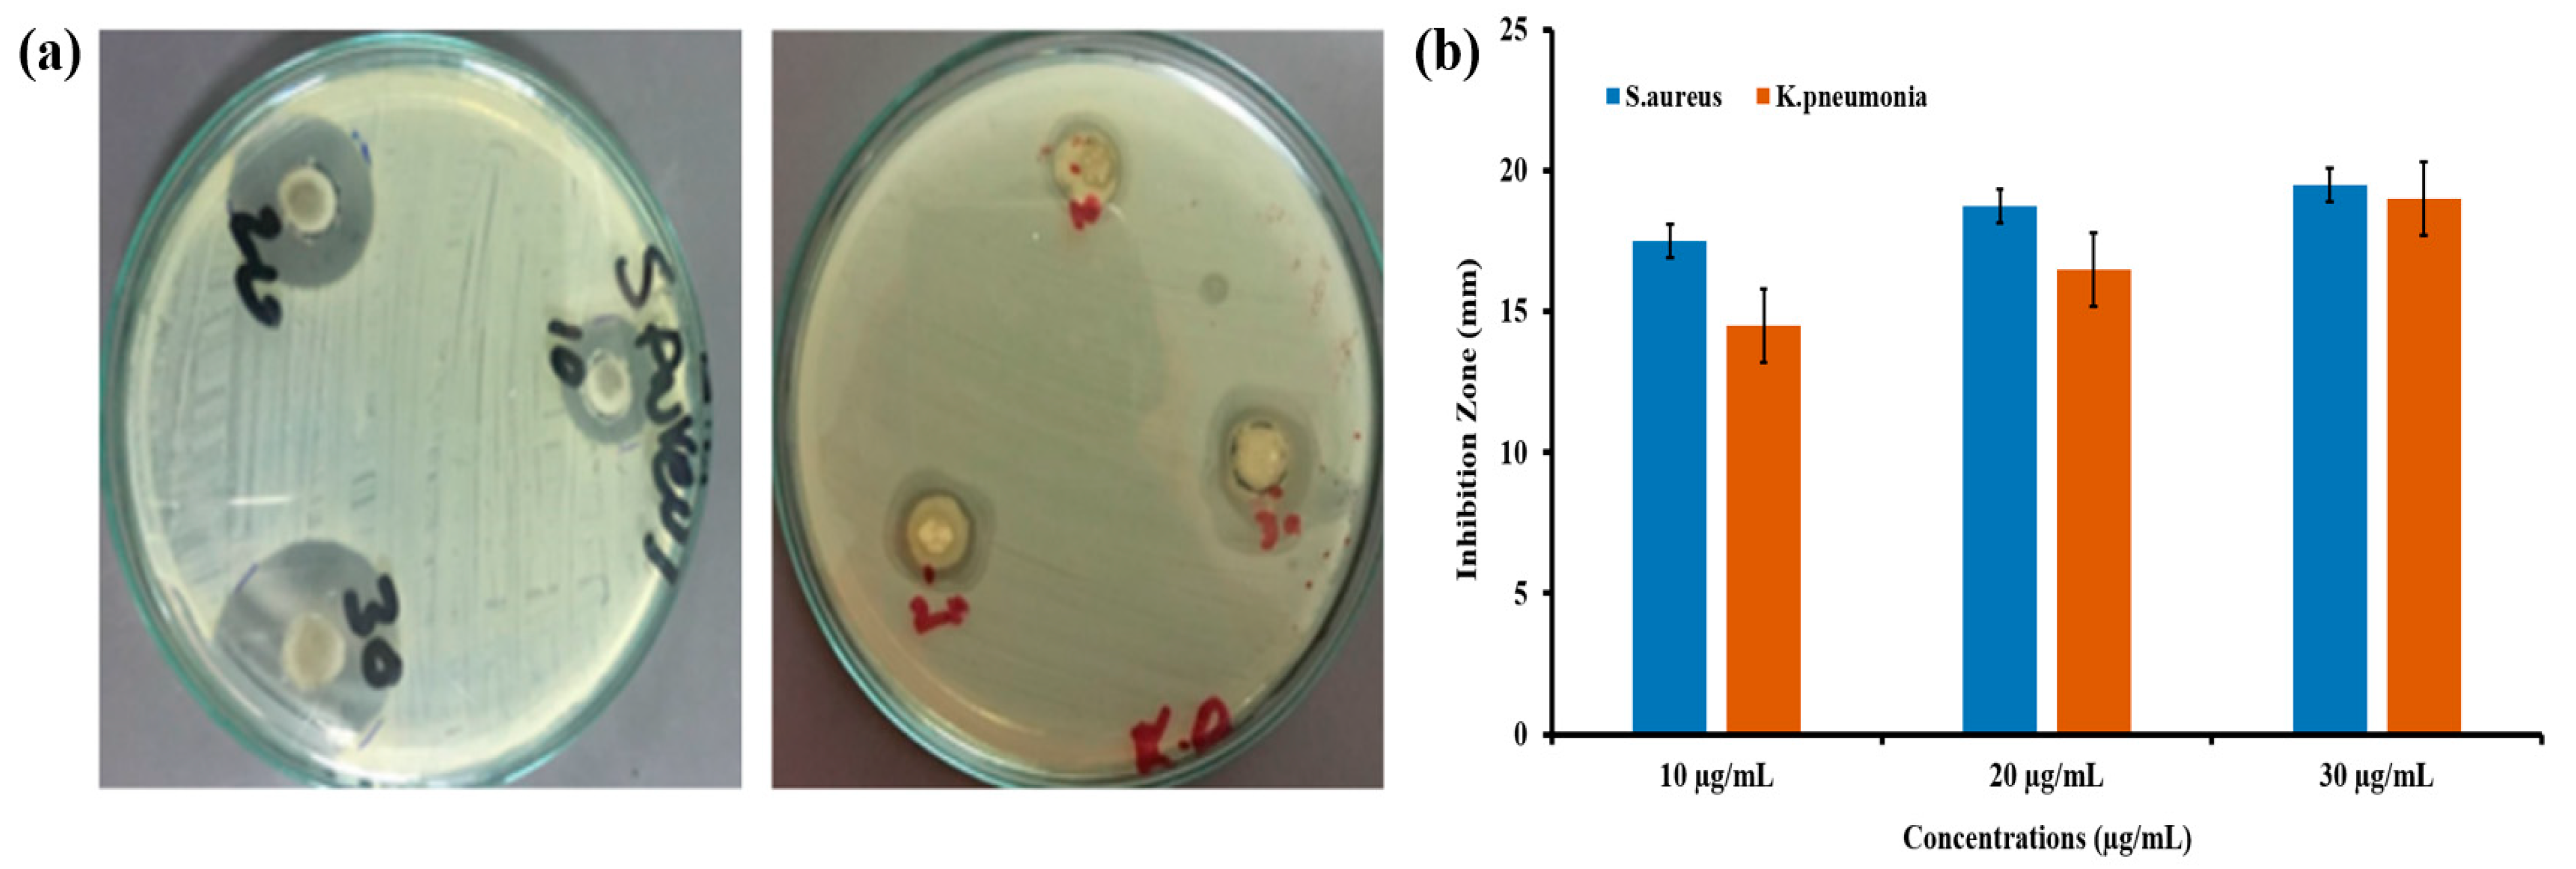

Green Synthesis of CeO2 Nanoparticles from the Abelmoschus esculentus Extract: Evaluation of Antioxidant, Anticancer, Antibacterial, and Wound-Healing Activities
Abstract
:1. Introduction
2. Materials and Methods
2.1. Materials
2.2. Green Synthesis of CeO2 Nanoparticles
2.3. Characterization
2.4. Antioxidant Activity
2.5. Cell Culturing and Exposure with CeO2 Nanoparticles
2.6. In Vitro Measurement of Cellular Cytotoxicity (MTT Assay)
2.7. HeLa Cells Morphological Analysis
2.8. Antibacterial Study
2.9. Chitosan Hydrogel–CeO2 Composite Membranes Preparation
2.10. Wound-Healing Activity
2.10.1. Swelling Percent of Chitosan Hydrogel–CeO2 Membranes
2.10.2. Animal Trial
2.11. Statistical Analysis
3. Results and Discussion
3.1. X-Ray Diffraction Analysis
3.2. SEM Analysis
3.3. UV-Visible Analysis
3.4. FT-IR Analysis

3.5. Antioxidant Activity of Green Synthesized CeO2 NPs Mediated Abelmoschus Esculentus
3.6. Evaluation of Anticancer Activity of Green Synthesized CeO2 NPs Mediated Abelmoschus Esculentus
3.7. Antibacterial Activity of Green Synthesized CeO2 NPs Mediated Abelmoschus Esculentus
3.8. Wound-Healing Potential of Green Synthesized CeO2 NPs Mediated Abelmoschus Esculentus
3.8.1. Swelling Studies of Hydrogel Membrane
3.8.2. Animal Trials
4. Conclusions
Author Contributions
Funding
Institutional Review Board Statement
Informed Consent Statement
Data Availability Statement
Acknowledgments
Conflicts of Interest
Sample Availability
References
- Singh, J.; Dutta, T.; Kim, K.H.; Rawat, M.; Samddar, P.; Kumar, P. ‘Green’ synthesis of metals and their oxide nanoparticles: Applications for environmental remediation. J. Nanobiotechnol. 2018, 16, 84. [Google Scholar] [CrossRef]
- Makarov, V.V.; Love, A.J.; Sinitsyna, O.V.; Makarova, S.S.; Yaminsky, I.V.; Taliansky, M.E.; Kalinina, N.O. “Green” nanotechnologies: Synthesis of metal nanoparticles using plants. Acta Nat. 2014, 6, 20. [Google Scholar] [CrossRef] [Green Version]
- Yadi, M.; Mostafavi, E.; Saleh, B.; Davaran, S.; Aliyeva, I.; Khalilov, R.; Nikzamir, M.; Nikzamir, N.; Akbarzadeh, A.; Panahi, Y.; et al. Current developments in green synthesis of metallic nanoparticles using plant extracts: A review. Artif. Cells Nanomed. Biotechnol. 2018, 46, 336–343. [Google Scholar] [CrossRef] [PubMed] [Green Version]
- Deshpande, S.; Patil, S.; Kuchibhatla, S.V.; Seal, S. Size dependency variation in lattice parameter and valency states in nanocrystalline cerium oxide. Appl. Phys. Lett. 2005, 87, 133. [Google Scholar] [CrossRef]
- Das, S.; Dowding, J.M.; Klump, K.E.; McGinnis, J.F.; Self, W.; Seal, S. Cerium oxide nanoparticles: Applications and prospects in nanomedicine. Nanomedicine 2013, 8, 1483–1508. [Google Scholar] [CrossRef]
- Xu, C.; Qu, X. Cerium oxide nanoparticle: A remarkably versatile rare earth nanomaterial for biological applications. NPG Asia Mater. 2014, 6, e90. [Google Scholar] [CrossRef]
- Beaudoux, X.; Virot, M.; Chave, T.; Durand, G.; Leturcq, G.; Nikitenko, S.I. Vitamin C boosts ceria-based catalyst recycling. Green Chem. 2016, 18, 3656–3668. [Google Scholar] [CrossRef]
- Aalapati, S.; Ganapathy, S.; Manapuram, S.; Anumolu, G.; Prakya, B.M. Toxicity and bio-accumulation of inhaled cerium oxide nanoparticles in CD1 mice. Nanotoxicology 2014, 8, 786–798. [Google Scholar] [CrossRef]
- Maqbool, Q. Green-synthesised cerium oxide nanostructures (CeO 2-NS) show excellent biocompatibility for phyto-cultures as compared to silver nanostructures (Ag-NS). RSC Adv. 2017, 7, 56575–56585. [Google Scholar] [CrossRef] [Green Version]
- Eming, S.A.; Martin, P.; Tomic-Canic, M. Wound repair and regeneration: Mechanisms, signaling, and translation. Sci. Transl. Med. 2014, 6, 265. [Google Scholar] [CrossRef] [PubMed] [Green Version]
- Delavary, B.M.; van der Veer, W.M.; van Egmond, M.; Niessen, F.B.; Beelen, R.H. Macrophages in skin injury and repair. Immunobiology 2011, 216, 753–762. [Google Scholar] [CrossRef]
- Demidova-Rice, T.N.; Durham, J.T.; Herman, I.M. Wound healing angiogenesis: Innovations and challenges in acute and chronic wound healing. Adv. Wound Care 2012, 1, 17–22. [Google Scholar] [CrossRef]
- Mohammadinejad, R.; Karimi, S.; Iravani, S.; Varma, R.S. Plant-derived nanostructures: Types and applications. Green Chem. 2016, 18, 20–52. [Google Scholar] [CrossRef]
- El Shafey, A.M. Green synthesis of metal and metal oxide nanoparticles from plant leaf extracts and their applications: A review. Green Process. Synth. 2020, 9, 304–339. [Google Scholar] [CrossRef]
- Ahmed, B.T.; Kumar, S.A. Antioxidant and Antidiabetic properties of Abelmoschus esculentus extract–an in vitro assay. Res. J. Biotechnol. 2016, 11, 34–41. [Google Scholar]
- Arapitsas, P. Identification and quantification of polyphenolic compounds from okra seeds and skins. Food Chem. 2008, 110, 1041–1045. [Google Scholar] [CrossRef] [PubMed]
- Xia, F.; Zhong, Y.; Li, M.; Chang, Q.; Liao, Y.; Liu, X.; Pan, R. Antioxidant and anti-fatigue constituents of okra. Nutrients 2015, 7, 8846–8858. [Google Scholar] [CrossRef] [PubMed] [Green Version]
- Rajput, N. Methods of preparation of nanoparticles-a review. Int. J. Adv. Eng. Technol. 2015, 7, 1806. [Google Scholar]
- Fabiano, B.; Reverberi, A.P.; Varbanov, P.S. Safety opportunities for the synthesis of metal nanoparticles and short-cut approach to workplace risk evaluation. J. Clean. Prod. 2019, 209, 297–308. [Google Scholar] [CrossRef]
- Duan, H.; Wang, D.; Li, Y. Green chemistry for nanoparticle synthesis. Chem. Soc. Rev. 2015, 44, 5778–5792. [Google Scholar] [CrossRef]
- Ahmed, S.; Chaudhry, S.A.; Ikram, S. A review on biogenic synthesis of ZnO nanoparticles using plant extracts and microbes: A prospect towards green chemistry. J. Photochem. Photobiol. B Biol. 2017, 166, 272–284. [Google Scholar] [CrossRef]
- Das, D.; Nath, B.C.; Phukon, P.; Dolui, S.K. Synthesis and evaluation of antioxidant and antibacterial behavior of CuO nanoparticles. Colloids Surf. B Biointerfaces 2013, 101, 430–433. [Google Scholar] [CrossRef] [PubMed]
- Fakhar-e-Alam, M.; Rahim, S.; Atif, M.; Aziz, M.H.; Malick, M.I.; Zaidi, S.S.Z.; Suleman, R.; Majid, A. ZnO nanoparticles as drug delivery agent for photodynamic therapy. Laser Phys. Lett. 2013, 11, 25601. [Google Scholar] [CrossRef]
- AlSalhi, M.S.; Aziz, M.H.; Atif, M.; Fatima, M.; Shaheen, F.; Devanesan, S.; Farooq, W.A. Synthesis of NiO nanoparticles and their evaluation for photodynamic therapy against HeLa cancer cells. J. King Saud Univ. -Sci. 2020, 32, 1395–1402. [Google Scholar] [CrossRef]
- Van Meerloo, J.; Kaspers, G.J.; Cloos, J. Cell sensitivity assays: The MTT assay. In Cancer Cell Culture; Humana Press: Totowa, NJ, USA, 2011; pp. 237–245. [Google Scholar]
- Gurunathan, S. Biologically synthesized silver nanoparticles enhances antibiotic activity against Gram-negative bacteria. J. Ind. Eng. Chem. 2015, 29, 217–226. [Google Scholar] [CrossRef]
- Gotoh, T.; Nakatani, Y.; Sakohara, S. Novel synthesis of thermosensitive porous hydrogels. J. Appl. Polym. Sci. 1998, 69, 895–906. [Google Scholar] [CrossRef]
- Kalantari, K.; Mostafavi, E.; Afifi, A.M.; Izadiyan, Z.; Jahangirian, H.; Rafiee-Moghaddam, R.; Webster, T.J. Wound dressings functionalized with silver nanoparticles: Promises and pitfalls. Nanoscale 2020, 12, 2268–2291. [Google Scholar] [CrossRef]
- Goharshadi, E.K.; Mahvelati, T.; Yazdanbakhsh, M. Influence of preparation methods of microwave, sol–gel, and hydrothermal on structural and optical properties of lanthania nanoparticles. J. Iran. Chem. Soc. 2016, 13, 65–72. [Google Scholar] [CrossRef]
- Tao, Y.; Gong, F.H.; Wang, H.; Wu, H.P.; Tao, G.L. Microwave-assisted preparation of cerium dioxide nanocubes. Mater. Chem. Phys. 2008, 112, 973–976. [Google Scholar] [CrossRef]
- Nadeem, M.; Khan, R.; Afridi, K.; Nadhman, A.; Ullah, S.; Faisal, S.; Mabood, Z.U.; Hano, C.; Abbasi, B.H. Green Synthesis of Cerium Oxide Nanoparticles (CeO2 NPs) and Their Antimicrobial Applications: A Review. Int. J. Nanomed. 2020, 15, 5951–5961. [Google Scholar] [CrossRef]
- Arumugam, A.; Karthikeyan, C.; Hameed, A.S.H.; Gopinath, K.; Gowri, S.; Karthika, V. Synthesis of cerium oxide nanoparticles using Gloriosa superba L. leaf extract and their structural, optical and antibacterial properties. Mater. Sci. Eng. C 2015, 49, 408–415. [Google Scholar] [CrossRef]
- Kannan, S.K.; Sundrarajan, M. A green approach for the synthesis of a cerium oxide nanoparticle: Characterization and antibacterial activity. Int. J. Nanosci. 2014, 13, 1450018. [Google Scholar] [CrossRef]
- Fortunati, E.; Puglia, D.; Monti, M.; Santulli, C.; Maniruzzaman, M.; Kenny, J.M. Cellulose nanocrystals extracted from okra fibers in PVA nanocomposites. J. Appl. Polym. Sci. 2013, 128, 3220–3230. [Google Scholar] [CrossRef]
- Leppänen, K.; Andersson, S.; Torkkeli, M.; Knaapila, M.; Kotelnikova, N.; Serimaa, R. Structure of cellulose and microcrystalline cellulose from various wood species, cotton and flax studied by X-ray scattering. Cellulose 2009, 16, 999–1015. [Google Scholar] [CrossRef]
- Maryam, S.; Khan, M.R.; Shah, S.A.; Zahra, Z.; Majid, M.; Sajid, M.; Ali, S. In vitro antioxidant efficacy and the therapeutic potential of Wendlandia heynei (Schult.) Santapau & Merchant against bisphenol A-induced hepatotoxicity in rats. Toxicol. Res. 2018, 7, 1173–1190. [Google Scholar]
- Kovacic, P.; Somanathan, R. Nanoparticles: Toxicity, radicals, electron transfer, and antioxidants. Oxidative Stress Nanotechnol. 2013, 15–35. [Google Scholar] [CrossRef]
- Zare, M.; Namratha, K.; Byrappa, K.; Surendra, D.M.; Yallappa, S.; Hungund, B. Surfactant assisted solvothermal synthesis of ZnO nanoparticles and study of their antimicrobial and antioxidant properties. J. Mater. Sci. Technol. 2018, 34, 1035–1043. [Google Scholar] [CrossRef]
- Miri, A.; Sarani, M. Biosynthesis, characterization and cytotoxic activity of CeO2 nanoparticles. Ceram. Int. 2018, 44, 12642–12647. [Google Scholar] [CrossRef]
- Nourmohammadi, E.; Oskuee, R.K.; Hasanzadeh, L.; Mohajeri, M.; Hashemzadeh, A.; Rezayi, M.; Darroudi, M. Cytotoxic activity of greener synthesis of cerium oxide nanoparticles using carrageenan towards a WEHI 164 cancer cell line. Ceram. Int. 2018, 44, 19570–19575. [Google Scholar] [CrossRef]
- Atif, M.; Firdous, S.; Khurshid, A.; Noreen, L.; Zaidi, S.; Ikram, M. In Vitro Study of 5-Aminolevulinic Acid-Based Photodynamic Therapy for Apoptosis in Human Cervical HeLa Cell Line. Laser Phys. Lett. 2009, 6, 886. [Google Scholar] [CrossRef]
- Atif, M.; Iqbal, S.; Fakhar-e-Alam, M.; Mansoor, Q.; Alimgeer, K.; Fatehmulla, A.; Hanif, A.; Yaqub, N.; Farooq, W.; Ahmad, S. Manganese-Doped Cerium Oxide Nanocomposite as a Therapeutic Agent for MCF-7 Adenocarcinoma Cell Line. Saudi J. Biol. Sci. 2021, 28, 1233–1238. [Google Scholar] [CrossRef] [PubMed]
- Atif, M.; Iqbal, S.; Ismail, M.; Mansoor, Q.; Mughal, L.; Aziz, M.H.; Hanif, A.; Farooq, W. Manganese-Doped Cerium Oxide Nanocomposite Induced Photodynamic Therapy in MCF-7 Cancer Cells and Antibacterial Activity. BioMed Res. Int. 2019, 2019, 7156828. [Google Scholar] [CrossRef] [PubMed] [Green Version]
- Atif, M.; Fakhar-e-Alam, M.; Firdous, S.; Zaidi, S.; Suleman, R.; Ikram, M. Study of the Efficacy of 5-ALA Mediated Photodynamic Therapy on Human Rhabdomyosarcoma Cell Line (RD). Laser Phys. Lett. 2010, 7, 757. [Google Scholar] [CrossRef]
- Lord, M.S.; Berret, J.F.; Singh, S.; Vinu, A.; Karakoti, A.S. Redox Active Cerium Oxide Nanoparticles: Current Status and Burning Issues. arXiv 2021, arXiv:2106.06473. [Google Scholar]
- Gumustas, M.; Sengel-Turk, C.T.; Gumustas, A.; Ozkan, S.A.; Uslu, B. Effect of polymer-based nanoparticles on the assay of antimicrobial drug delivery systems. Multifunct. Syst. Comb. Deliv. Biosens. Diagn. 2017, 67–108. [Google Scholar] [CrossRef]
- Irshad, M.S.; Aziz, M.H.; Fatima, M.; Rehman, S.U.; Idrees, M.; Rana, S.; Shaheen, F.; Ahmed, A.; Javed, M.Q.; Huang, Q. Green synthesis, cytotoxicity, antioxidant and photocatalytic activity of CeO2 nanoparticles mediated via orange peel extract (OPE). Mater. Res. Express 2019, 6, 950. [Google Scholar] [CrossRef]
- Burello, E.; Worth, A.P. A theoretical framework for predicting the oxidative stress potential of oxide nanoparticles. Nanotoxicology 2011, 5, 228–235. [Google Scholar] [CrossRef]
- Mohandas, A.; Deepthi, S.; Biswas, R.; Jayakumar, R. Chitosan based metallic nanocomposite scaffolds as antimicrobial wound dressings. Bioact. Mater. 2018, 3, 267–277. [Google Scholar] [CrossRef]
- Zgheib, C.; Hilton, S.A.; Dewberry, L.C.; Hodges, M.M.; Ghatak, S.; Xu, J.; Singh, S.; Roy, S.; Sen, C.K.; Seal, S.; et al. Use of cerium oxide nanoparticles conjugated with microRNA-146a to correct the diabetic wound healing impairment. J. Am. Coll. Surg. 2019, 228, 107–115. [Google Scholar] [CrossRef]

Publisher’s Note: MDPI stays neutral with regard to jurisdictional claims in published maps and institutional affiliations. |
© 2021 by the authors. Licensee MDPI, Basel, Switzerland. This article is an open access article distributed under the terms and conditions of the Creative Commons Attribution (CC BY) license (https://creativecommons.org/licenses/by/4.0/).
Share and Cite
Ahmed, H.E.; Iqbal, Y.; Aziz, M.H.; Atif, M.; Batool, Z.; Hanif, A.; Yaqub, N.; Farooq, W.A.; Ahmad, S.; Fatehmulla, A.; et al. Green Synthesis of CeO2 Nanoparticles from the Abelmoschus esculentus Extract: Evaluation of Antioxidant, Anticancer, Antibacterial, and Wound-Healing Activities. Molecules 2021, 26, 4659. https://doi.org/10.3390/molecules26154659
Ahmed HE, Iqbal Y, Aziz MH, Atif M, Batool Z, Hanif A, Yaqub N, Farooq WA, Ahmad S, Fatehmulla A, et al. Green Synthesis of CeO2 Nanoparticles from the Abelmoschus esculentus Extract: Evaluation of Antioxidant, Anticancer, Antibacterial, and Wound-Healing Activities. Molecules. 2021; 26(15):4659. https://doi.org/10.3390/molecules26154659
Chicago/Turabian StyleAhmed, Hafiz Ejaz, Yasir Iqbal, Muhammad Hammad Aziz, Muhammad Atif, Zahida Batool, Atif Hanif, Nafeesah Yaqub, W. A. Farooq, Shafiq Ahmad, Amanullah Fatehmulla, and et al. 2021. "Green Synthesis of CeO2 Nanoparticles from the Abelmoschus esculentus Extract: Evaluation of Antioxidant, Anticancer, Antibacterial, and Wound-Healing Activities" Molecules 26, no. 15: 4659. https://doi.org/10.3390/molecules26154659
APA StyleAhmed, H. E., Iqbal, Y., Aziz, M. H., Atif, M., Batool, Z., Hanif, A., Yaqub, N., Farooq, W. A., Ahmad, S., Fatehmulla, A., & Ahmad, H. (2021). Green Synthesis of CeO2 Nanoparticles from the Abelmoschus esculentus Extract: Evaluation of Antioxidant, Anticancer, Antibacterial, and Wound-Healing Activities. Molecules, 26(15), 4659. https://doi.org/10.3390/molecules26154659

